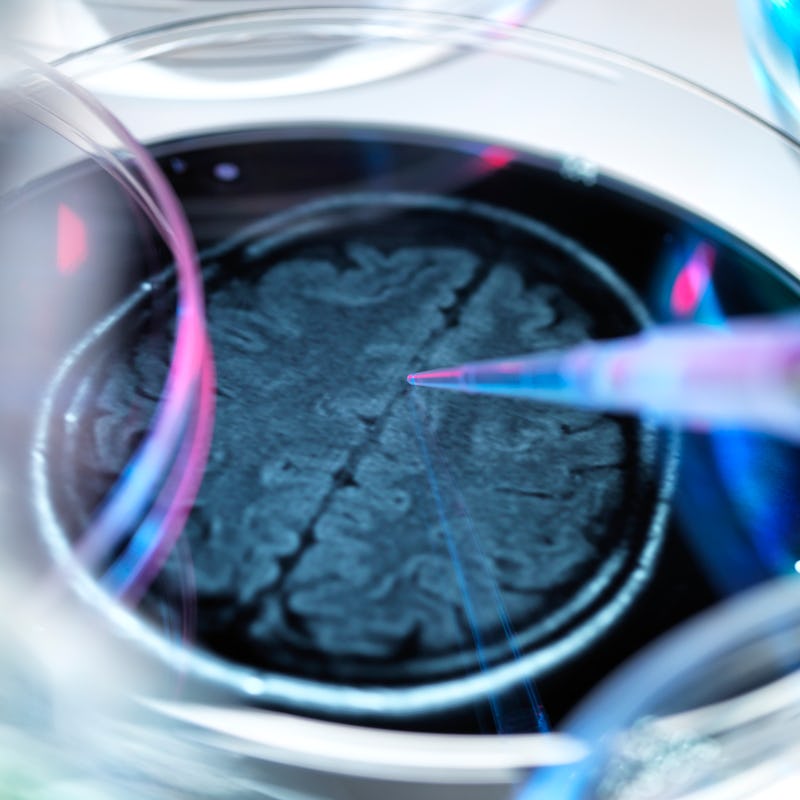

Alzheimer's disease has no cure — but unproven treatments claim otherwise
“If you don’t want to believe it until there is a clinical trial, fine.”
The Reverse Alzheimer’s Summit 2022, an online event held last month, presented a grab bag of purported solutions to one of the world’s most dreaded diseases.
Speakers (some well-known in alternative medicine circles) blamed head trauma, mold, bad oral health, and neglect of care for the skull for contributing to the disease.
As for remedies, you could take your pick. Speakers touted the keto diet, hormone therapy, and time in a hyperbaric oxygen tank. One has an eight-week plan for “reversal of biological aging” that claims to take off three years’ worth of decline. Another authored a book on the “healing power of music” for brain health. This was the third summit organized under one central premise.
“Solutions exist. Alzheimer’s is optional,” summit organizer Heather Sandison, a naturopath and self-described “neurohacker,” tells Inverse. “The hard work is changing the narrative, so people know to get help early. So many are suffering unnecessarily.”
Sandison is so confident she founded a $3,500-a-month care home in Vista, California, that claims to be “the only senior living facility with a goal for residents to return to independent living.”
“There is nothing that can reverse [Alzheimer’s].”
This message counters the consensus of mainstream neurology, which holds that dementia (the syndrome of age-related loss of one’s faculties) and Alzheimer’s disease (the most common form of dementia) are not reversible under current scientific knowledge.
“At the moment, there are treatments available, which are looking to slow progression of the disease or symptoms, but there is nothing that can reverse [Alzheimer’s] and not a proven way to definitively prevent Alzheimer’s disease or dementia,” says Claire Sexton, a research scientist and director of scientific programs and outreach at the Alzheimer’s Association.
Still, to the frustration of some neurologists, a groundswell of Alzheimer’s books and services have, in recent years, touted a “reversal,” “end,” “elixir,” “solution,” or “antidote.” Amazon’s list of top-selling Alzheimer’s-related titles is glutted with lifestyle guides and holistic protocols, alongside a few caregiver’s guides and dementia-friendly puzzle and game books.
Among those titles is always The End of Alzheimer’s, a New York Times bestseller by Dale Bredesen, a former UCLA neurologist, a guest of honor at the Reverse Alzheimer’s Summit, and the father of the idea that one can reverse cognitive decline through lifestyle changes — particularly the $1,400 “Bredesen Protocol” offered by his network of health care providers.
There is a sunnier outlook than offered by mainstream neurology. As the number of people with Alzheimer’s has ballooned, thanks to increases in life expectancy in the last two decades, mainstream science has offered no promising new treatments, relying mostly on an arsenal of decades-old dementia drugs that can only slow the disease.
Aduhelm, which squeaked past U.S. Food and Drug Administration approval last year to become the first new Alzheimer’s drug since 2003, is rarely covered by insurers or prescribed by doctors because of its high cost and lingering questions about its effectiveness. It only highlighted Big Pharma’s ineptitude against dementia, which afflicted 6.5 million Americans in 2020 and is on course to impact 14 million by 2060.
Some patients and their families have turned to an alternative health world that is increasingly self-assured about its power over cognitive decline.
A family matter
An illustration showing a human nerve cell affected by Lewy bodies (red).
Dinah, who lives in an isolated town in a U.S. mountain state, says she read more than 20 books on brain health after her husband was diagnosed with Lewy body dementia.
“Everyone seems to have the same basic idea,” she says. “You need healthy fat to regrow the brain.” (Dinah asked that we not use her real name to protect her husband’s privacy.)
Lewy body dementia, a disease similar to Alzheimer’s, made her husband unrecognizably volatile and angry. He can’t find household items and blames her. “He would be kicking me in bed, screaming in bed, holding me,” Dinah says. “The next morning, he doesn’t remember anything.”
She picked three sources for treatment: “orthomolecular medicine” advocate Andrew Saul, whose website recommends vitamins for dementia; Men Are from Mars, Women Are from Venus author John Gray, who advocates lithium orotate to regenerate brain cells; and the Bredesen protocol.
They saw a doctor, but Dinah was disappointed by his slow response time and hesitancy about alternative approaches, like testing her husband for mold toxicity. (Mycotoxins are frequent villains in alternative Alzheimer’s circles, but their association with dementia is not well established.)
Saul has been rebuffed for spreading misinformation about vitamin C and Covid-19, and claims made on Gray’s vitamin-selling website elicited a warning from the FDA. (Inverse reached out to both Saul and Gray for comment for this story and received no response.)
But experimenting with all treatments, even ones outside the mainstream, gives Dinah something she yearns for: A sense of control.
“I know I am doing everything I can for my husband,” she says.
Seeking: An intervention that works
An illustration of the tau protein (orange) interrupting brain processes in Alzheimer’s disease.
To mainstream neurologists, the pathology of Alzheimer’s and other kinds of dementia is still mysterious. Clumps of a protein called tau and buildup of amyloid plaques form in the brain. Early symptoms include the inability to form new memories, confusion, poor concentration, and diminished vocabulary. As the disease progresses and the brain shrinks, the patient can lose memory, speech, and motor function. They eventually die from some complication of their weakened body’s inability to function.
Life factors have been shown to increase the risk of dementia. Population-based studies, which track the habits and health outcomes of a large number of people over time, link Alzheimer’s to a variety of unfortunate conditions: physical inactivity, low educational attainment, mid-life obesity, hypertension, diabetes, and depression.
“You can have any kind of lifestyle and develop dementia and Alzheimer’s.”
Studies have also shown that people who engage in mentally stimulating activities, drink alcohol only moderately, and eat a healthy diet are less likely to develop it.
To mainstream science, these are interesting discoveries — even reasons for hope for a fuller understanding of dementia — but you can’t flip a risk factor and tell patients that, if they start living healthier, signs of dementia that are already showing will decline.
“For most of these risk factors, we have not seen an interventional study,” says Alzheimer’s Association scientist Sexton, “so more research is needed before we can recommend those interventions.”
She adds, “You can have any kind of lifestyle and develop dementia and Alzheimer’s.”
Still, some alternative-health professionals have come to see Alzheimer’s as primarily a treatable lifestyle issue.
A network insufficiency
A portrait of Dale Bredesen, taken while he was president and CEO of The Buck Institute in 2004.
The End of Alzheimer’s author Dale Bredesen is a physician with a lofty résumé, including tenures as chief resident in neurology at UCSF and director of UCLA’s Alzheimer’s research center. For most of his career, he authored papers with unsexy titles like “Apoptosis and dependence receptors: a molecular basis for cellular addiction.” He wanted to do something more.
“I worked on basic science, chemistry, mostly,” Bredesen tells Inverse. “So what I wanted to do was set up my own laboratory… to understand the basic mechanism: What is the molecular biology of the neurodegenerative process? And then I didn’t know if we’d ever have enough information to begin to translate that to what you would do for a human being to make them better.”
In 2014, he decided he did. The UCLA press office released a statement entitled, “Memory loss associated with Alzheimer’s reversed for first time.”
Bredesen believes Alzheimer’s “is a network insufficiency.”
“Just like if you are too low in vitamin D, you get rickets. If you’re too low in vitamin C, you get scurvy,” he says. “In this case, you have a mismatch of the demand of this very extensive synaptic network and the supply.” A lack of things that energize or grow the brain or the presence of inflammation or toxins that separate the brain from its needs disrupt this network, he says.
With that 2014 announcement, Bredesen reported that he treated ten patients with cognitive decline using lifestyle changes, and nine showed improvement. For the three described in some detail, he reconfigured their diets, created regimens of vitamins and supplements, and had them start exercise routines.
“Multiple red flags appear in the scientific studies supporting the Bredesen protocol.”
What he had published was a case series, a group of anecdotal reports of patients given similar treatment, which doesn’t have the controls of a clinical trial. The results also can’t be replicated, a cornerstone of scientific discovery.
Neurologist John Ringman saw patients with familial Alzheimer’s at UCLA, while Bredesen’s work spurred that 2014 press release.
“I had to field a flurry of phone calls from families affected by this horrible form of AD that can begin as early as one’s 30s,” Ringman says, “and I had to tell them it wasn’t true that we had a cure.”
In 2016, Bredesen published a second case series with another ten patients. He transmuted this work into The End of Alzheimer’s and into the Bredesen protocol, in which patients undergo blood tests to determine which of 36 health factors could “cause” their cognitive decline and then work to eliminate them.
Supply and demand
Dale Bredesen recommends taking certain supplements as part of the Bredesen Protocol.
The Bredesen protocol is not cheap. Initial costs average $3,000 in diagnostic tests and visits to a Bredesen-trained health care provider, says Bredesen. Access to an online program for patients costs $75 a month.
More than 2,000 health care providers of varying backgrounds and qualifications have taken his training, which costs $1,500.
In 2018, armed with reports from this network, he put out another case series of 100 patients.
Bredesen has authored a book of supposed success stories, The First Survivors of Alzheimer’s, and sells supplements costing between $40 and $65 for a 30-day supply. A month’s worth of all the supplements recommended for his protocol costs $349.
It is an empire built on the idea that dementia is reversible.
And it has generated skepticism, even warnings, from fellow neurologists.
In 2020, Joanna Hellmuth, a neurologist at the University of California San Francisco, wrote an opinion piece titled “Can we trust The End of Alzheimer’s?” for The Lancet.
“When carefully examined, multiple red flags appear in the scientific studies supporting the Bredesen protocol,” she wrote. “To date, the evidence does not support its claim to prevent and reverse cognitive decline.”
“I think a lot of people in neurology have been very disheartened by this,” Hellmuth tells Inverse, “and by seeing so many people swept up in it.”
“It’s got a lot of aura of science.”
Hellmuth and others criticize Bredesen for building his church on the rock of case series.
“Since the authors do not have a non-treatment (control) group and also use a radically individualized methodology, the only comparisons possible are between the same patients before and after their study,” wrote neuro-ethicist Timothy Daly in an article in Theoretical Medicine and Bioethics.
“Yet the three papers provide only sparse descriptions of patients’ cognitive decline. They do not convey how radical the changes due to the protocol were in patients’ lives; all they allege is that the protocol helped them improve.”
Another frequent complaint stems from where Bredesen published these case series.
If you look for that 2018 study of 100 patients in PubMed, the National Institutes of Health-run online index of biomedical research, you won’t find it. PubMed took out all the material from the parent company of the journal that published it, OMICS Publishing Group, after it was fined $50 million by the Federal Trade Commission. OMICS was accused of “predatory publishing,” a practice of collecting fees from researchers who want their work published, while maintaining few editorial standards.
Aging, the journal that published the 2014 and 2016 case studies, has been accused of the same.
“It’s got a lot of aura of science,” Hellmuth says, “but unfortunately, in my opinion, this is very low-quality science, and he is very well-trained. He has the skills, and he has the knowledge to do better science, and I think the question is: Why doesn’t he?”
Trials on trial
Clinical trials are the gold standard of treatment development.
Bredesen says he has wanted to do a clinical trial of his protocol with a control group since 2011, but an institutional review board (the group at a research organization that approves studies) didn’t allow it, arguing: What can you prove with a 36-step plan, where everyone gets a different treatment?
“[I]t was not allowed because we were saying something new: This is a multi-variable disease,” he says. “You’ve got to go after it with a protocol, not a single drug.” He says he is preparing for a clinical trial now.
Bredesen says if he took the 2014 case series to the prestigious New England Journal of Medicine (“where it should have been published”), “they are going to go to an expert who believes in the old-fashioned way of doing this and he’s biased,” he says. “There’s bias everywhere.”
When asked about critiques of his work, Bredesen often veers back to the shortcomings of mainstream medicine.
“As they say: ‘Any fool can criticize, and most fools do,’” he says. “I’m happy to debate these people at any time. Let’s talk about why we’re doing what we’re doing, and let’s talk about: Do you have something better? No one has something that even comes close to what we published.”
Bredesen accuses his peers of callously waiting for scientific consensus that meets their lofty standards while the body count from dementia illnesses stacks up.
“We are breaking the mold.”
“If you don’t want to believe it until there is a clinical trial, fine,” Bredesen says of his own protocol, “but you will have people coming in, dying needlessly.”
He adds: “Whereas we have Silicon Valley doing all kinds of novel things and all sorts of disruption, medicine is about tradition and permission, and so, yes, we are breaking the mold and doing something different.”
Bredesen says he is gearing up for a more comprehensive study. In July of this year, he published “a proof-of-concept trial.” He and his collaborators recruited 25 people with mild cognitive impairment or dementia and treated them with “a personalized, precision medicine protocol,” the approach he has been selling for years.
After nine months, 19 improved their scores on the Montreal Cognitive Assessment, a common screening test for mild cognitive impairment and Alzheimer’s disease. The study authors listed nine limitations, including a lack of participants diagnosed with Alzheimer’s (the headline on Bredesen’s website blared: “Evidence That Early Alzheimer’s Can Be Reversed”) and a lack of a control group.
Peers again expressed reservations. Eric Verdin, current president and CEO of the Buck Institute for Research on Aging (a post Bredesen once held), told a local paper that “rigorous clinical trials involving his protocols would be necessary to reach any definitive conclusions as to their effectiveness.” But the study’s main intention was to argue a more comprehensive one is warranted.
Ringman, Bredesen’s former UCLA colleague, says he continues to be asked about Bredesen’s protocol. Recently, one of his patients wanted to try it. “I told her what he’s selling is unproven, but it probably isn’t hurting anyone, so let the buyer beware.”
Raising red flags
Dementia and Alzheimer’s patients are often left without clear options.
As evidenced by the days of speakers at the Reverse Alzheimer’s Summits, Bredesen is not the only figure with ideas that sometimes clash with mainstream neurology asking for the trust of Alzheimer’s patients.
Dean and Ayesha Sherzai, a husband-and-wife team who are co-directors of the Brain Health and Alzheimer’s Prevention Program at Loma Linda University, are the authors of The Alzheimer’s Solution, published by an imprint of HarperCollins, one of the world’s largest publishing houses.
The book lays out a guide to nutrition, exercise, sleep, relaxation, and mental stimulation that “reduces risk of Alzheimer’s disease by 90 percent,” according to a banner on its cover.
This is a bold claim. When estimating how many Alzheimer’s cases could, theoretically, be prevented through better living, other researchers have been much more conservative. A brain trust of experts, published in The Lancet in 2020, examined 12 major risk factors and estimated that they account for 40 percent of cases worldwide.
The Alzheimer’s Solution claims it is “the only scientifically proven solution to the international epidemic of Alzheimer’s” in its introduction. But despite both Sherzais having lengthy research résumés, there has never been a published clinical trial of its approach, dubbed the NEURO Plan.
The Sherzais did not respond to several emails seeking an interview. Their publisher, HarperOne, did not respond to an email asking what data supports that 90-percent figure.
Some people claiming they can reverse Alzheimer’s have more exotic opinions.
“‘Reverse Alzheimer’s’ is a red flag.”
Michelle Honda, author of Reverse Alzheimer’s Disease Naturally, writes in an email to Inverse that dementia is mostly an issue of malnutrition and patients “stop eating due to the decline of brain function continuing to take care of motor skills among most other cognitive functions. They may, of course, die from heart or kidney failure, etc., but if they do not succumb to another ailment, it is because the body is no longer getting nourishment.”
Honda also asserts that “You will never get dementia if you take in long-chained fatty acids which directly support brain tissue of which are only marine sourced.”
This is not a mainstream view of the mechanisms of Alzheimer’s disease. Also, according to the U.K.-based Alzheimer’s Society Against Dementia, “the research evidence on fish oils to date is contradictory” and “mixed.”
Neurologists are frequently asked about these sorts of ideas, so they have boned up on their knowledge of them.
“So many people ask, mainly out of the despair and fear that goes with a very scary disease,” says Michal Schnaider Beeri, a dementia researcher and professor of psychiatry at Mount Sinai’s Icahn School of Medicine. To answer questions about it, Beeri read Bredesen’s The End of Alzheimer’s. “I would not tell [a patient] to do it,” she says. “I would say that it hasn’t been proven.”
Madhav Thambisetty, a clinical neurologist and senior investigator at the National Institute of Aging, says he keeps materials from “reversal” methods in his office and gives patients an explainer of the scientific evidence-gathering process and how they fall short of it. “This empowers them to make decisions.”
He said that many of these Alzheimer’s approaches are dubious.
“‘Reverse Alzheimer’s’ is a red flag. ‘Prevent Alzheimer’s’ is a red flag. ‘Revolutionary’ is another one,” he says. “Anything that couches things in these absolute terms is always a red flag, and that’s something that patients need to be warned about.”
He adds, “The common feature running through all of these is there is very little scientific evidence to back up these claims, either in terms of peer-reviewed publications or well-controlled clinical trials.”
Another way forward
Actively encouraging healthy lifestyle behaviors and social engagement may stave off cognitive decline in old age.
It is not impossible to conduct a study of lifestyle changes on cognitive decline. But it is slow, hard, and expensive, and the conclusions may not be definitive.
But some researchers are beginning to do just that.
The most lauded such research project is the Finger (Finnish Geriatric Intervention) Study. In 2009, with funding from 15 different agencies and foundations, Finnish researchers recruited 1,260 people aged 60 to 77. None had been diagnosed with dementia, but their cognitive abilities were below average for their age.
They were split into two groups. Over the course of two years, the intervention group received a remarkable level of personalized care. Nutritionists met with them individually to create diet plans high in foods correlated to mental longevity. Physiotherapists oversaw their physical exercise routines and psychologists their cognitive ones. They met in groups for these programs to foster socialization.
A control group had three sessions with a nurse who discussed the importance of diet, exercise, socialization, and cognitive engagement. The study authors called this “regular health advice.” It acted as a placebo.
“To show that lifestyle factors can be targeted and slow cognitive decline is a very exciting finding.”
After 24 months, the intervention group did 25 percent better on a series of cognitive tests than the control group, according to findings published in The Lancet in 2015. The researchers did not claim a cure or reversal of dementia. The conclusion? The “model needs to be investigated further, particularly with regard to the contribution of each component to the overall effect,” the study read.
Thambisetty from the National Institute of Aging says this shows a responsible way to test holistic approaches to dementia. “To be able to show that lifestyle factors can be targeted and can slow cognitive decline, in of itself, is a very exciting finding,” he says. Several countries are launching Finger-like studies to build on the data.
“I think the way we move forward with Finger and studies like Finger is we design similar trials for diverse populations and then be able to test whether or not these findings hold together,” says Thambisetty.
As for now, Thambisetty stresses that dementia patients and their families are vulnerable, and they could be nudged toward an unproven treatment and devastated when it doesn’t work.
“Not only are we giving patients a diagnosis of an irreversible neurodegenerative disease, we are also putting their family members in great distress by giving them that diagnosis,” he says. “I think that makes it all the more important to make sure that their expectations from such interventions are realistic.”